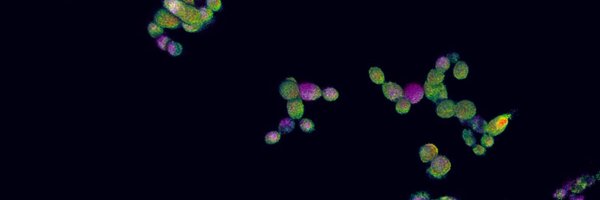
lindskalan Profile Banner

Dr. Lindsay Kalan 🇨🇦
@lindskalan
Followers
779
Following
3K
Media
24
Statuses
1K
Associate Professor @BBS_McMasterU and @UWMadisonMMI interested in microbes and how they interact with each other and with us.
Burlington, ON
Joined April 2016
Large-scale investigation for antimicrobial activity reveals novel defensive species across the healthy skin microbiome https://t.co/yawcIdiL5d
#biorxiv_micrbio
0
5
8
Check out our latest study presenting a new skin microbiome isolate collection demonstrating extensive antimicrobial activity. This was a long-term and huge team effort led by @uyenthynguyen, Shelby Sandstrom, and @SalamMicrobes. #skinmicrobiome #amr
Large-scale investigation for antimicrobial activity reveals novel defensive species across the healthy skin microbiome https://t.co/yawcIdiL5d
#biorxiv_micrbio
0
2
11
What I don't get about academia is the chronic lack of celebration. It is hard to get & maintain grant funding, hard to get papers accepted without Faustian bargains, hard to be a great mentor, & hard to maximize trainee success. All of it is hard. We should celebrate everything.
49
206
2K
Check out our latest tool to find BGCs and explore their evolution and diversity within a single lineage. Includes tools for visualization and detailed reports! Interested in other types of gene clusters? Check out Zol & Fai
github.com
zol (& fai): large-scale targeted detection and evolutionary investigation of gene clusters (i.e. BGCs, phages, etc.) - Kalan-Lab/zol
1
4
11
Our latest paper assesses the impact of antiseptics on the viable skin microbiome. The #skinmicrobiome is highly viable and resilient to insult but resistant pathogens are selected for increasing the risk of infection in the short term.
biorxiv.org
Surgical site infections (SSI) continue to occur despite widespread adoption of surgical antiseptics. The effects of chlorhexidine gluconate (CHG)-based antiseptics on the skin microbiome also...
0
4
12
I just returned from #Woundheal2024 feeling reinvigorated. The most exciting part was celebrating the awards lab trainees won! @LizCTown won a travel award for top trainee abstract and @jz_alexcheong took home first place in the Young Investigator Symposium! #whs #dfu
0
1
7
Very excited to share our new research in collaboration with @lindskalan lab in @mbiojournal ! Key aspects of papillomavirus infection influence the host cervicovaginal microbiome in a preclinical murine papillomavirus (MmuPV1) infection model | mBio
journals.asm.org
Human papillomaviruses (HPVs) are the most common sexually transmitted infection in the United States. A subset of HPVs that infect the anogenital tract (cervix, vagina, anus) and oral cavity cause...
4
5
15
Thank-you @McMasterIIDR for the support, I'm looking forward to this collaboration and fun project!
While traditional cell culturing practices are effective, they are labour intensive and time consuming. Thankfully, @lindskalan, @surette_m, and @TohidDidar are working to streamline these processes by applying microfluidic and microdroplet approaches to microbiome research.
0
0
7
Newest lab preprint from the fabulous @maryhswaney Skin-associated Corynebacterium amycolatum shares cobamides https://t.co/c4DNppr6TN
#skinmicrobiome #corynebacterium
biorxiv.org
The underlying interactions that occur to maintain skin microbiome composition, function, and overall skin health are largely unknown. Often, these types of interactions are mediated by microbial...
0
2
8
Five exceptional researchers from the Faculty of Health Sciences have been awarded new and renewed Canada Research Chairs. Congratulations to @Andrew_P_Costa, P.J. Devereaux, @lindskalan, @Sloboda_Lab @MGVanstone on this prestigious achievement! https://t.co/VH9YoMYwBZ
healthsci.mcmaster.ca
The federal government has invested more than $5 million in five researchers from McMaster University’s Faculty of Health Sciences who have been named Canada Research Chairs. Researchers Andrew...
2
15
65
Super honored that @lindskalan and I’s review article, "Living in Your Skin: Microbes, Molecules and Mechanisms", was highlighted as an @ASMicrobiology Top Cited paper in 2023! https://t.co/mdo4kd2L7Y
0
3
18
With our annual Trainee Day symposium just one week away, it’s time to meet some of our amazing speakers and award winners!
1
1
7
Check out our latest! We used a combination of clinical indicators, quantitative microbiology, microscopy, sequencing and proteomics to characterize the “gunk” that forms on top of wounds. Turns out that this “gunk” can be useful to predict healing times! @LizCTown
What is Slough?A pilot study to define the proteomic and microbial composition of wound slough and its implications for wound healing. https://t.co/WbVeSZqhQW
#biorxiv_micrbio
1
5
9
Interested in doing a PhD with me in Sweden? Experimental+computational genomics skills or interests? We have an open position! Great environment at KTH on @SciLifeLab campus, staff benefits, well-funded project, close interactions with our New York team. Link in the replies 👇
3
73
132
Eek so excited for this! Alex is the first PhD graduate from the lab and he will be talking about a little bit of everything #DFU. From polymicrobial #biofilms to model #skinmicrobiome systems and #metatranscriptomics.
Join us on Friday (7/28) at 1:30 PM in 1220 Microbial Sciences Building for an exciting #MDTP thesis defense seminar! Alex Cheong (@jz_alexcheong) from Kalan Lab (@lindskalan) will present his work on "Multiscale characterization of the diabetic foot ulcer microbiome"
0
3
20
Come join us!
Exciting work on the skin microbiome from @lindskalan @McMasterIIDR linking bacterial metabolism in wounds to clinical outcomes (outstanding #biofilm microbiology too). She's hiring a post-doc! Superb opportunity, energetic young PI, terrific environment #HavingIMPACTT2023
0
8
25
We are looking for a new Faculty Research Assistant to come do fungal bacterial interaction research and more. apps due 16 July, info at
0
38
45
#MDTP Student Highlight: Thy Nguyen Thy (@uyenthynguyen) is a graduate student working in @lindskalan lab studying skin microbiome. She is currently in the Toronto area, so she has been exploring the city and trying out new foods. #UWMadison
1
3
6